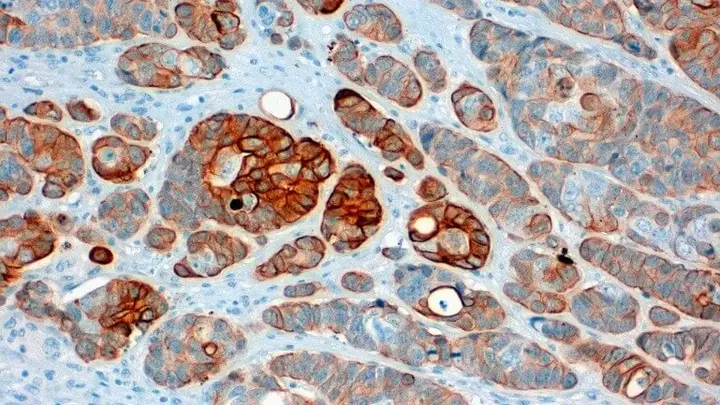

Die Aufarbeitung der histologischen Proben erfolgt in den Eingangslaboratorien an den Standorten Campus Nord und Campus Süd. Dort sind insgesamt 30 Labormitarbeiterinnen und -mitarbeiter tätig – von der Assistenz im Zuschnitt über die Aufarbeitung und Färbung feingeweblicher Proben bis hin zu immunhistologischen Spezialuntersuchungen.
Histopathologie am Klinikum Nürnberg
Was ist Histopathologie?

Die Histopathologie ist ein Teilbereich der Pathologie und bezeichnet die morphologische Analyse von krankhaft verändertem Gewebe.
Diese Analyse umfasst meist sowohl eine makroskopische (mit bloßem Auge fassbare) als auch eine mikroskopische (feingewebliche) Beurteilung von Gewebeproben.
Was sind Spezialfärbungen?
Spezialfärbungen sind histochemische Färbemethoden, mit denen bestimmte Gewebebestandteile, Stoffwechselprodukte oder Mikroorganismen gezielt sichtbar gemacht werden können. Sie ergänzen die Standardfärbung und helfen, spezielle diagnostische Fragestellungen zu klären. Beispiele sind die Elastica-von-Gieson-Färbung (Darstellung elastischer Fasern und von Bindegewebe), die Eisenfärbung (Nachweis von ionisiertem Eisen), die PAS-Reaktion (Darstellung von Glykogen, Basalmembranen und Pilzen), die Ziehl-Neelsen-Färbung (Nachweis säurefester Stäbchen) sowie die Gramfärbung zum Nachweis grampositiver Bakterien.
Schnellschnittdiagnostik (intraoperative Diagnostik)
Die Schnellschnittdiagnostik ermöglicht eine schnelle vorläufige Befundung von Gewebeproben während einer laufenden Operation, insbesondere bei Tumorverdacht. Die Probe wird nativ (ohne Formalin) in die Pathologie gebracht, dort makroskopisch beurteilt, eingefroren (ca. −20 °C), geschnitten und im Schnellverfahren gefärbt. Innerhalb von etwa 15–20 Minuten kann das Ergebnis telefonisch übermittelt werden und das operative Vorgehen unterstützen.
Die Schnellschnittuntersuchung dient der Beantwortung spezieller intraoperativer Fragestellungen und ersetzt nicht die reguläre histologische Aufarbeitung in Paraffin.
Wichtige Hinweise:
- Material nativ (ohne Formalin) einsenden
- Probe umgehend an die Pathologie weiterleiten
- Schnellschnitt telefonisch im Labor anmelden
- Rückrufnummer unbedingt auf dem Antrag angeben
Was ist Immunhistochemie?

Eine wichtige Rolle spielt die Immunhistochemie (Antikörperfärbung). Mit dieser speziellen Färbemethode werden bestimmte Proteinstrukturen im Gewebe sichtbar gemacht, was eine präzise Tumortypisierung und wichtige Hinweise für individuelle Therapieentscheidungen ermöglicht.
Am Universitätsinstitut für Pathologie sind mehr als 200 diagnostisch relevante Antikörper etabliert. Wir arbeiten mit modernen Vollautomaten und führen die Untersuchungen nach den Vorgaben der DAkkS-Akkreditierung sowie IVDR-konform durch.
Zur kontinuierlichen Qualitätssicherung nehmen wir regelmäßig an Ringversuchen der Qualitätssicherungs-Initiative Pathologie (QuiP) teil und wirken teilweise auch als Lead- bzw. Panel-Institut an deren Durchführung mit.